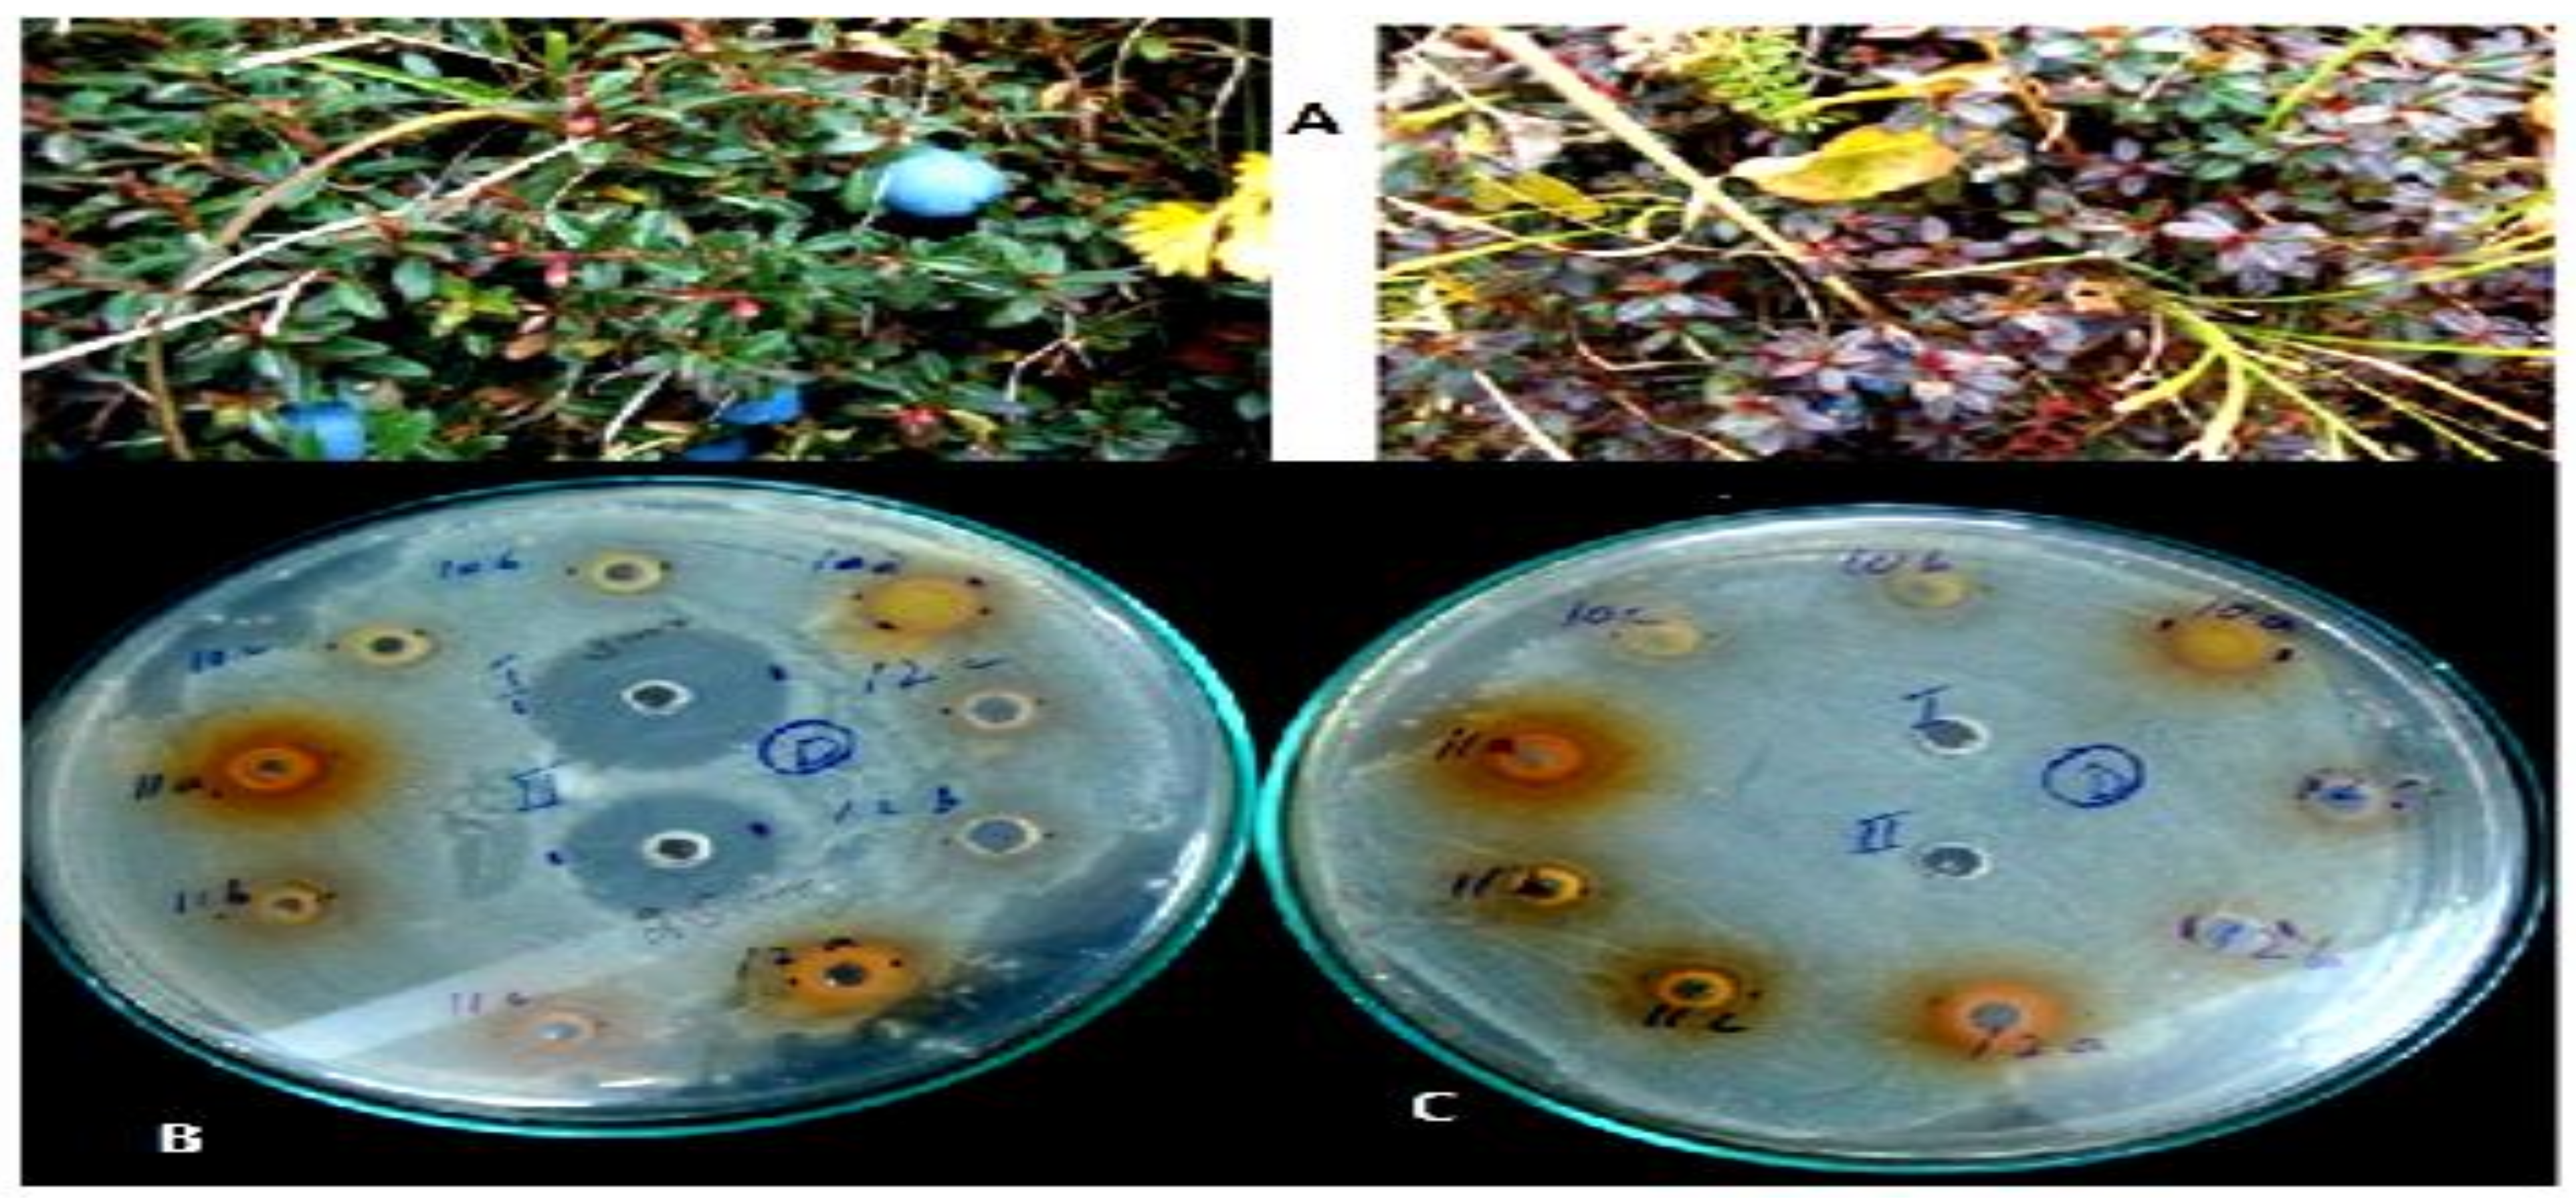
Applsci 12 06921 g004

Phytochemical, Antimicrobial and Cytotoxic Activities of Gaultheria Trichophylla Royle
Abstract
:1. Introduction
2. Materials and Methods
2.1. The Plant Material
2.2. Pharmacognostic Studies
2.3. Phytochemical Studies
2.4. Elemental Analysis
2.5. Cytotoxic Activity
2.6. Antifungal Activity
2.7. Antibacterial Activity
2.8. Statisctical Analysis
3. Results
3.1. Pharmacognostic Studies
3.2. Qualitative Analysis
3.3. Quantitative Estimation of Phytochemical
3.4. Elemental Analysis
3.5. Cytotoxic Assay
3.6. Antifungal Assay
3.7. Antibacterial Assay
4. Discussion
5. Conclusions
Author Contributions
Funding
Institutional Review Board Statement
Informed Consent Statement
Acknowledgments
Conflicts of Interest
References
- Luo, B.S.; Gu, R.H.; Kennelly, E.J.; Long, C.L. Gaultheria ethnobotany and bioactivity: Blueberry relatives with anti-inflammatory, antioxidant, and anticancer constituents. Curr. Med. Chem. 2018, 25, 5168–5176. [Google Scholar] [CrossRef] [PubMed]
- Choudhary, R.K.; Lee, J. A floristic reconnaissance of Churdhar wildlife sanctuary of Himachal Pradesh, India. Manthan Int. J. 2012, 13, 2–12. [Google Scholar]
- Bisht, C.; Badoni, A. Medicinal strength of some alpine and sub-alpine zones of western Himalaya, India. N. Y. Sci. J. 2009, 2, 41–46. [Google Scholar]
- Zhang, D.; Liu, R.; Sun, L.; Huang, C.; Wang, C.; Zhang, D.M.; Du, G.H. Anti-inflammatory activity of methyl salicylate glycosides isolated from Gaultheria yunnanensis (Franch.) Rehder. Molecules 2011, 16, 3875–3884. [Google Scholar] [CrossRef] [Green Version]
- Dutt, B.; Sharma, S.; Sharma, K.; Gupta, A.; Singh, H. Ethnobotanical survey of plants used by Gaddi tribe of Bharmour area in Himachal Pradesh. Himal. Ecol. 2011, 19, 22–27. [Google Scholar]
- Dogra, K.S.; Chauhan, S.; Jalal, J.S. Assessment of Indian medicinal plants for the treatment of asthma. J. Med. Plants Res. 2015, 9, 851–862. [Google Scholar]
- Luo, B.; Kastrat, E.; Morcol, T.; Cheng, H.; Kennelly, E.; Long, C. Gaultheria longibracteolata, An alternative source of wintergreen oil. Food Chem. 2021, 342, 128244. [Google Scholar] [CrossRef] [PubMed]
- Sultana, S.; Khan, M.A.; Ahmad, M.; Bano, A.; Zafar, M.; Shinwari, Z.K. Authentication of herbal medicine neem (Azadirachta indica A. Juss.) by using taxonomic and pharmacognostic techniques. Pak. J. Bot. 2011, 43, 141–150. [Google Scholar]
- Khan, M.A.; Ahmad, M.; Zafar, M.; Sultana, S.; Marwat, S.K.; Shaheen, S.; Nazir, A. Medico-botanical and chemical standardization of pharmaceutically important plant of Tricholepischaetolepis (Boiss) Rech. f. J. Med. Plant Res. 2011, 5, 1471–1477. [Google Scholar]
- Handa, S.S. Indian efforts for quality control and standardization of herbal drugs/products. In Proceedings of the 1st Joint Workshop on Quality Control and Standardization of Traditional Medicine Indo-China Experience, Lucknow, India, 8–10 January 2004; pp. 8–10. [Google Scholar]
- Alamgir, A.N.M. Origin, definition, scope and area, subject matter, importance, and history of development of pharmacognosy. In Therapeutic Use of Medicinal Plants and Their Extracts; Springer: Cham, Switzerland, 2017; pp. 19–60. [Google Scholar]
- Wei, G.; Fu, X.; Wang, Z. Multi solvent Similarity Measure of Chinese Herbal Medicine Ingredients for Cold–Hot Nature Identification. J. Chem. Inf. Model. 2019, 59, 5065–5073. [Google Scholar] [CrossRef]
- Zbinden, P.; Andrey, D. Determination of trace element contaminants in food matrices using a robust: Routine analytical method for ICP-MS. At. Spectrosc. 1998, 19, 214–219. [Google Scholar]
- Sadia, H.; Ahmad, M.; Sultana, S.; Abdullah, A.Z.; Teong, L.; Zafar, M.; Bano, A. Nutrient and mineral assessment of edible wild fig and mulberry fruits. Fruits 2014, 69, 159–166. [Google Scholar] [CrossRef] [Green Version]
- Jilani, M.I.; Ahmad, M.I.; Hanif, R.; Nadeem, R.; Hanif, M.A.; Khan, M.A.; Iqbal, T. Proximate analysis and mineral profile of three elite cultivars of Rosa hybrida flowers. Pak. J. Bot. 2012, 44, 1711–1714. [Google Scholar]
- Shaul, O. Magnesium transport and function in plants: The tip of the iceberg. Biometals 2002, 15, 307–321. [Google Scholar] [CrossRef]
- Soylaka, M.; Saraçoğlub, S.; Tüzenc, M.; Mendil, D. Determination of trace metals in mushroom samples from Kayseri, Turkey. Food Chem. 2005, 92, 649–652. [Google Scholar] [CrossRef]
- Beevi, S.S.; Mangamoori, L.N.; Gowda, B.B. Polyphenolics profile and antioxidant properties of Raphanus sativus L. Nat. Prod. Res. 2012, 26, 557–663. [Google Scholar] [CrossRef]
- Laura, A.; Moreno-Escamilla, J.O.; Rodrigo-García, J.; Alvarez-Parrilla, E. Phenolic compounds. In Postharvest Physiology and Biochemistry of Fruits and Vegetables; Woodhead Publishing: Cambridge, UK, 2019; pp. 253–271. [Google Scholar]
- Kampkötter, A.; Nkwonkam, C.G.; Zurawski, R.F.; Timpel, C.; Chovolou, Y.; Wätjen, W.; Kahl, R. Investigations of protective effects of the flavonoids quercetin and rutin on stress resistance in the model organism Caenorhabditis elegans. Toxicology 2007, 234, 113–123. [Google Scholar] [CrossRef]
- Mostafa, A.A.; Al-Askar, A.A.; Almaary, K.S.; Dawoud, T.M.; Sholkamy, E.N.; Bakri, M.M. Antimicrobial activity of some plant extracts against bacterial strains causing food poisoning diseases. Saudi J. Biol. Sci. 2018, 25, 361–366. [Google Scholar] [CrossRef]
- Huang, H.; Deng, J.; Lan, Y.; Yang, A.; Zhang, L.; Wen, S.; Deng, Y. Detection of helminthosporium leaf blotch disease based on UAV imagery. Appl. Sci. 2019, 9, 558. [Google Scholar] [CrossRef] [Green Version]
- Yan, H.; Nelson, B., Jr. Effect of temperature on Fusarium solani and F. tricinctum growth and disease development in soybean. Can. J. Plant Pathol. 2020, 42, 527–537. [Google Scholar] [CrossRef]
- Fernandez, N.B.; Caceres, D.H.; Beer, K.D.; Irrazabal, C.; Delgado, G.; Farias, L.; Stecher, D. Ventilator-associated pneumonia involving Aspergillus flavus in a patient with coronavirus disease 2019 (COVID-19) from Argentina. Med. Mycol. Case Rep. 2021, 31, 19–23. [Google Scholar] [CrossRef] [PubMed]
- Morelli, K.A.; Kerkaert, J.D.; Cramer, R.A. Aspergillus fumigatus biofilms: Toward understanding how growth as a multicellular network increases antifungal resistance and disease progression. PLoS Pathog. 2021, 17, e1009794. [Google Scholar] [CrossRef] [PubMed]
- Halliwell, B.; Gutteridge, J.M. Free Radicals in Biology and Medicine; Oxford University Press: New York, NY, USA, 2015. [Google Scholar]
- Da Silva, A.R.A.; de Morais, S.M.; Mendes Marques, M.M.; de Oliveira, D.F.; Barros, C.C.; de Almeida, R.R.; Guedes, M.I.F. Chemical composition, antioxidant and antibacterial activities of two Spondias species from Northeastern Brazil. Pharm Biol. 2012, 50, 740–746. [Google Scholar] [CrossRef] [PubMed]
- De Rosa, S.; De Giulio, A.; Iodice, C. Biological effects of prenylated hydroquinones: Structure-activity relationship studies in antimicrobial, brine shrimp, and fish lethality assays. J. Nat. Prod. 1994, 57, 1711–1716. [Google Scholar] [CrossRef]
- Castello, M.C.; Phatak, A.; Chandra, N.; Sharon, M. Antimicrobial activity of crude extracts from plant parts and corresponding calli of Bixa orellana L. Ind. J. Exp. Biol. 2002, 40, 1378–1381. [Google Scholar]
- Ayandele, A.A.; Adebiyi, A.O. The phytochemical analysis and antimicrobial screening of extracts of Olax subscorpioidea. Afr. J. Biotechnol. 2007, 6. [Google Scholar] [CrossRef]
- Kim, J.H.; Tam, C.C.; Chan, K.L.; Mahoney, N.; Cheng, L.W.; Friedman, M.; Land, K.M. Antimicrobial Efficacy of edible Mushroom extracts: Assessment of Fungal resistance. Appl. Sci. 2022, 12, 4591. [Google Scholar] [CrossRef]
- Robbers, J.E.; Speedie, M.K.; Tyler, V.E. Pharmacognosy and Pharmacobiotechnology; Williams & Wilkins: Philadelphia, PA, USA, 1996. [Google Scholar]
- Wang, Y.H.; Lu, L.; Wang, Y.H.; Wang, H. The survey of plant germplasm resources and evaluation of application on Chinese Gaultheria. J. Yunnan Univ. 2013, 35, 378–389. [Google Scholar]
- Ma, X.J.; Zheng, J.H.; Chen, X.Z. Studies on resources of ethnomedicine Gaultheria leucocarpa var. yunnanensis. J. Chin. Mater. Med. 2001, 26, 85–89. [Google Scholar]
- Jamil, M.; Mirza, B.; Qayyum, M. Isolation of antibacterial compounds from Quercus dilatata L. through bioassay guided fractionation. Ann. Clin. Microbiol. 2012, 11, 1–11. [Google Scholar] [CrossRef] [Green Version]
- Trease, G.E.; Evans, W.C. A Textbook of Pharmacognosy, 12th ed.; Bailliere Tindall: London, UK, 1989; pp. 480–502. [Google Scholar]
- Ahmad, M.; Khan, M.A.; Zafar, M.; Arshad, M.; Sultana, S.; Abbasi, B.H. Use of chemotaxonomic markers for misidentified medicinal plants used in traditional medicines. J. Med. Plant Res. 2010, 4, 1244–1252. [Google Scholar]
- Harborne, J.B. Phytochemical Methods; Chapman and Halls: London, UK, 1998. [Google Scholar]
- Singleton, V.L.; Rossi, J.A. Colorimetry of total phenolics with phosphomolybdic-phosphotungstic acid reagents. Am. J. Enol. Vitic. 1965, 16, 144–158. [Google Scholar]
- Sakanaka, S.; Tachibana, Y.; Okada, Y. Preparation and antioxidant properties of extracts of Japanese persimmon leaf tea (kakinoha-cha). Food Chem. 2005, 89, 569–575. [Google Scholar] [CrossRef]
- Allen, S.E. Chemical Analysis of Ecological Material; Blackwell Scientific Publications: Hoboken, NJ, USA, 1989. [Google Scholar]
- Meyer-Alber, A.; Hartmann, H.; Stümpel, F.; Creutzfeldt, W. Mechanism of insulin resistance in CCl4-induced cirrhosis of rats. Gastroenterology 1992, 102, 223–229. [Google Scholar] [CrossRef]
- Duraipandiyan, V.; Ignacimuthu, S. Antibacterial and antifungal activity of Flindersine isolated from the traditional medicinal plant, Toddalia asiatica (L.) Lam. J. Ethnopharmacol. 2009, 123, 494–498. [Google Scholar] [CrossRef]
- Bagamboula, C.F.; Uyttendaele, M.; Debevere, J. Antimicrobial effect of spices and herbs on Shigella sonnei and Shigella flexneri. J. Food Prot. 2003, 66, 668–673. [Google Scholar] [CrossRef]
- Khan, A.S.; Ihsan, I.; Shah, A.A.; Razia, B. Preliminary phytochemical screening of some plants of ethnobotanical importance from district Gilgit of Northern Areas, Pakistan. Hamdard Med. 2010, 53, 102–105. [Google Scholar]
- Sofowora, A. Medicinal Plants and Traditional Medicines in Africa; John Wiley & Sons: New York, NY, USA, 1993; pp. 97–145. [Google Scholar]
- Zhang, Z.; Guo, D.; Li, C.; Zheng, J.; Koike, K.; Jia, Z.; Nikaido, T. Gaultherins A and B, two lignans from Gaultheria yunnanensis. Phytochemistry 1999, 51, 469–472. [Google Scholar] [CrossRef]
- Alam, F.; Najum us Saqib, Q. Pharmacognostic standardization and preliminary phytochemical studies of Gaultheria trichophylla. Pharm. Biol. 2015, 53, 1711–1718. [Google Scholar] [CrossRef]
- Alam, F.; Ashraf, M. Gaultheria trichophylla (Royle): A source of minerals and biologically active molecules, its antioxidant and anti-lipoxygenase activities. BMC Complement. Altern. Med. 2017, 17, 3. [Google Scholar] [CrossRef] [Green Version]
- Bahukhandi, A.; Pandey, A.; Sekar, K.C.; Bhatt, I.D. Polyphenolics, nutrients and antioxidant activity of Gaultheria trichophylla Royle: A high value wild edible plant of Trans Himalaya. Horticult. Int. J. 2017, 1, 00007. [Google Scholar]
- Kabuki, T.; Nakajima, H.; Arai, M.; Ueda, S.; Kuwabara, Y.; Dosako, S.I. Characterization of novel antimicrobial compounds from mango (Mangifera indica L.) kernel seeds. Food Chem. 2000, 71, 61–66. [Google Scholar] [CrossRef]
- Aboaba, O.O.; Efuwape, B.M. Antibacterial properties of some Nigerian species. Bio Res. Comm. 2001, 13, 183–188. [Google Scholar]
- Mohanta, T.K.; Patra, J.K.; Rath, S.K.; Pal, D.K.; Thatoi, H.N. Evaluation of antimicrobial activity and phytochemical screening of oils and nuts of Semicarpusanacardium Lf. Sci. Res. Essay 2007, 2, 486–490. [Google Scholar]
- Narod, F.B.; Gurib-Fakim, A.; Subratty, A.H. Biological investigations into Antidesma madagascariense Lam. (Euphorbiaceae), Faujasiopsis flexuosa (Lam.) C. Jeffrey (Asteraceae), Toddalia asiatica (L.) Lam and Vepris lanceolata (Lam.) G. Don (Rutaceae). J. Cell Mol. Biol. 2004, 3, 15–21. [Google Scholar]
- Baydar, N.G.; Sagdic, O.; Ozkan, G.; Cetin, S. Determination of antibacterial effects and total phenolic contents of grape (Vitis vinifera L.) seed extracts. Int J. Food Sci. Technol. 2006, 41, 799–804. [Google Scholar] [CrossRef]
- Rodríguez, N.; Amils, R.; Jiménez-Ballesta, R.; Rufo, L.; de la Fuente, V. Heavy metal content in Erica andevalensis: An endemic plant from the extreme acidic environment of Tinto River and its soils. Arid Land Res. Manag. 2007, 21, 51–65. [Google Scholar] [CrossRef]
- Aligiannis, N.; Kalpoutzakis, E.; Mitaku, S.; Chinou, I.B. Composition and antimicrobial activity of the essential oils of two Origanum species. J. Agric. Food Chem. 2001, 49, 4168–4170. [Google Scholar] [CrossRef]

| S.No | Treatment | Under Visible Light | Under UV | On the Filter Paper Under Visible Light | On the Filter Paper Under UV Light | Solubility |
|---|---|---|---|---|---|---|
| 1 | Dried leaf powder | Pinkish green | Pinkish red | - | - | - |
| 2 | Powdered drug + 50% KOH | Woven slats | Milky green | Celery seed | Woven slats | Semi sol |
| 3 | Powdered drug + 10% aq. FeCl3 | Dark brown | Brownish black | Spiny green | Revival mahogany | Soluble |
| 4 | Powdered drug + dH2O | Transparent | Milky green | Egg shell | Spiny green | Semi sol |
| 5 | Powdered drug + HCl Conc | Woven slats | Brownish green | Glinted white | Spiny green | Soluble |
| 6 | Powdered drug + HCl 50% | Silk knot | Hidden green | Gardenia | Violet | Soluble |
| 7 | Powdered drug + H2SO4 Conc | Brownish black | Greenish brown | Chocolate | Greenish brown | Soluble |
| 8 | Powdered drug + H2SO4 50% | Dark cotton | Light brown | Hidden green | Willow branch | Semi sol |
| 9 | Powdered drug + HNO3 Conc | Golden | Brownish green | Glinted white | Revival mahogany | Soluble |
| 10 | Powdered drug + HNO3 50% | Golden | Hidden green | Glinted white | Violet | Soluble |
| 11 | Powdered drug + CH3OH Conc | Willow branch | Yellowish red | Gardenia | White | Soluble |
| 12 | Powdered drug + CH3OH 50% | Transparent | Single blade | Gardenia | Hidden green | Soluble |
| 13 | Powdered drug + CHCl3 Conc | Glinted white | Milkish red | Green whimsy | Sky shy | Soluble |
| 14 | Powdered drug + CHCl3 50% | Light leaf | Spring cut | Gardenia | Light leaf | Soluble |
| 15 | Powdered drug + C2H5OH Conc | Transparent | Milkish red | Gardenia | White | Soluble |
| 16 | Powdered drug + C2H5OH 50% | Transparent | Greenish whimsy | Gardenia | Hidden green | Soluble |
| 17 | Powdered drug + CH3COOH Conc | Light golden | Milky pink | Gardenia | White | Soluble |
| 18 | Powdered drug + CH3COOH 50% | Caramel cream | Spring cut | Gardenia | White | Soluble |
| 19 | Powdered drug + C6H6 Conc | Spiney green | Dark red | Gardenia | White | Soluble |
| 20 | Powdered drug + C6H6 50% | Light lichens | Bands of red and green | Light lichens | Red and spots of white lilac | Soluble |
| S.No | Treatment | Under Visible Light | Under UV | On the Filter Paper under Visible Light | On the Filter Paper under UV Light | Solubility |
|---|---|---|---|---|---|---|
| 1 | Dried leaf powder | Pinkish green | Pinkish red | - | - | - |
| 2 | Powdered drug + 50% KOH | Woven slats | Light brown | Celery seed | Violet | Semi sol |
| 3 | Powdered drug + 10% aq. FeCl3 | Green brown | Brownish black | Spiney green | Revival mahogany | Soluble |
| 4 | Powdered drug + dH2O | Light cotton | Milky green | Egg shell | Spiney green | Semi sol |
| 5 | Powdered drug + HClConc | Light brown | Pinkish brown | Glinted white | Spiney green | Soluble |
| 6 | Powdered drug + HCl 50% | Silk knot | Hidden green | Gardenia | Violet | Soluble |
| 7 | Powdered drug + H2SO4 Conc | Brownish black | Dark brown | Chocolate | Dark green | Soluble |
| 8 | Powdered drug + H2SO4 50% | light golden | Light brown | Hidden green | Willow branch | Soluble |
| 9 | Powdered drug + HNO3 Conc | Dark golden | Pinkish brown | Glinted white | Violet | Soluble |
| 10 | Powdered drug + HNO3 50% | Golden | Light brown | Glinted white | Violet | Soluble |
| 11 | Powdered drug + CH3OH Conc | Marsh green | Pinkish red | Gardenia | White | Soluble |
| 12 | Powdered drug + CH3OH 50% | Cotton | Single blade | Gardenia | Hidden green | Soluble |
| 13 | Powdered drug + CHCl3 Conc | Woven slats | Milkish red | Green whimsey | Sky shy | Soluble |
| 14 | Powdered drug + CHCl3 50% | Celery seed | Hidden green | Gardenia | White lilac | Soluble |
| 15 | Powdered drug + C2H5OH Conc | light golden | Milkish red | Gardenia | White | Soluble |
| 16 | Powdered drug + C2H5OH 50% | Cotton | Single blade | Gardenia | Hidden green | Soluble |
| 17 | Powdered drug + CH3COOH Conc | light golden | Milkish red | Gardenia | White | Soluble |
| 18 | Powdered drug + CH3COOH 50% | Silk knot | Hidden green | Gardenia | White | Soluble |
| 19 | Powdered drug + C6H6 Conc | Spiney green | Dark red | Gardenia | White | Soluble |
| 20 | Powdered drug + C6H6 50% | Light lichens | Bands of red and green | Light lichens | Red and spots of white lilac | Soluble |
| S.NO | Test | Result | Protocol Used |
|---|---|---|---|
| 1 | Flavonoid | + + | [38,45] |
| 2 | Saponin | + + | [38] |
| 3 | Tannins | + + | [46] |
| 4 | Phenolic | + + | [45] |
| 5 | Terpenoids | + + | [38] |
| 7 | Alkaloids | + + | [38] |
| S.No | Conc. (µg/mL) | No. of Live | No. of Dead | Percent Activity | LC50 |
|---|---|---|---|---|---|
| 1 | 1 | 8 | 2 | 20 | 50 µg/mL |
| 2 | 5 | 7 | 3 | 30 | |
| 3 | 10 | 7 | 3 | 30 | |
| 4 | 50 | 5 | 5 | 50 | |
| 5 | 100 | 5 | 5 | 50 | |
| 6 | 250 | 4 | 6 | 60 | |
| 7 | 500 | 1 | 9 | 90 | |
| 8 | 750 | 0 | 10 | 100 |
| % Inhibition of Various Fungal Species | ||||
|---|---|---|---|---|
| Treatment | Helminthosporiumsolani | Fusarium solani | Aspergillus flavus | Aspergillus fumigatus |
| Control | 86.33 ± 0.88 a | 77.3 ± 1.2 a | 84 ± 1.52 a | 86.66 ± 0.09 a |
| GTME | 71 ± 2.87 b | 58 ± 0.57 bc | 78 ± 2.886 b | 59 ± 5.19 bc |
| GTHE | 48.5 ± 3.75 d | 70 ± 1.154 ab | 35 ± 4.04 c | 53.5 ± 3.17 c |
| GTCE | 57 ± 2.89 c | 67.5 ± 0.29 b | 37 ± 0.577 c | 44 ± 1.54 d |
| GTEE | 58.5 ± 0.29 c | 72.5 ± 2.59 ab | 29 ± 1.154 cd | 61.5 ± 0.29 b |
| GTBE | 53 ± 4.04 cd | 65.5 ± 3.75 b | 37 ± 0.577 c | 55 ± 0.58 c |
| GTWE | 68 ± 4.04 b | 72 ± 0.57 ab | 30.5 ± 1.44 cd | 53 ± 4.04 c |
| Samples | Bacillus subtillis | Staphylococcus aureus | Escherichia coli | Pseudomonas aeruginosa | ||||||||
|---|---|---|---|---|---|---|---|---|---|---|---|---|
| 30 mg/mL | 15 mg/mL | 7.5 mg/mL | 30 mg/mL | 15 mg/mL | 7.5 mg/mL | 30 mg/mL | 15 mg/mL | 7.5 mg/mL | 30 mg/mL | 15 mg/mL | 7.5 mg/mL | |
| GTME | 14.5 ± 0.5 d | 11.5 ± 0.408 e | ND | 15.5 ± 0.25 cd | 13 ± 0 d | 11.5 ± 0.5 e | 13 ± 1 de | 10.5 ± 0.25 e | ND | 12.75 ± 0.75 de | 11.5 ± 0.25 e | 10 ± 1 ef |
| GTHE | ND | ND | ND | 13 ± 0.5 d | 11 ± 1 e | 10 ± 1 ef | 11.5 ± 0.5 e | ND | ND | 13.5 ± 0.5 d | 13.5 ± 0.5 d | 9.5 ± 0.5 f |
| GTCE | ND | ND | ND | 16 ± 0.5 c | 14 ± 2 cd | 12.5 ± 1.5 de | 16 ± 0 c | 11.5 ± 0.25 e | 11 ± 0 ce | 11.5 ± 0.5 e | 11 ± 0.5 e | 13.5 ± 0.5 d |
| GTEE | 16 ± 1 c | 13 ± 0.816 de | 11.5 ± 0.5 e | 20.5 ± 0.75 b | 14.5 ± 0.5 cd | 13.5 ± 0.5 d | 17.5 ± 0.5 bc | 13.5 ± 0.25 de | 12 ± 1 c | 20.5 ± 2.5 b | 11 ± 1.5 e | 11 ± 1 e |
| GTBE | 14.5 ± 0 d | 11.5 ± 0.408 e | 9.5 ± 0.5 f | 16.5 ± 0.25 c | 14.5 ± 0.5 cd | 12 ± 1 de | 16.5 ± 1.5 c | 12 ± 0 de | 10.5 ± 0.5 e | 17.5 ± 1.5 bc | 14.5 ± 0.25 c | 13.5 ± 0.5 d |
| GTWE | 14 ± 2 d | 11.5 ± 0.408 e | ND | 17.5 ± 0.25 bc | 15.5 ± 0.5 cd | 13 ± 0 d | 14.5 ± 0.5 d | 11 ± 0.5 e | 10.5 ± 1.5 e | 13 ± 0 d | 12.5 ± 0.75 de | 13 ± 1 d |
| PC-I | 27.5 ± 0.5 a | 27.5 ± 0.5 a | 27.5 ± 0.5 a | 27.5 ± 0.5 a | 27.5 ± 0.5 a | 27.5 ± 0.5 a | 27.5 ± 0.5 a | 27.5 ± 0.5 a | 27.5 ± 0.5 a | 27.5 ± 0.5 a | 27.5 ± 0.5 a | 27.5 ± 0.5 a |
| PC-II | 18.5 ± 0.5 b | 18.5 ± 0.5 b | 18.5 ± 0.5 b | 18.5 ± 0.5 b | 18.5 ± 0.5 b | 18.5 ± 0.5 b | 18.5 ± 0.5 b | 18.5 ± 0.5 b | 18.5 ± 0.5 b | 18.5 ± 0.5 b | 18.5 ± 0.5 b | 18.5 ± 0.5 b |
Publisher’s Note: MDPI stays neutral with regard to jurisdictional claims in published maps and institutional affiliations. |
© 2022 by the authors. Licensee MDPI, Basel, Switzerland. This article is an open access article distributed under the terms and conditions of the Creative Commons Attribution (CC BY) license (https://creativecommons.org/licenses/by/4.0/).
Share and Cite
Zaman, S.; Al-Joufi, F.A.; Zafar, M.; Zahoor, M. Phytochemical, Antimicrobial and Cytotoxic Activities of Gaultheria Trichophylla Royle. Appl. Sci. 2022, 12, 6921. https://doi.org/10.3390/app12146921
Zaman S, Al-Joufi FA, Zafar M, Zahoor M. Phytochemical, Antimicrobial and Cytotoxic Activities of Gaultheria Trichophylla Royle. Applied Sciences. 2022; 12(14):6921. https://doi.org/10.3390/app12146921
Chicago/Turabian StyleZaman, Shah, Fakhria A. Al-Joufi, Muhammad Zafar, and Muhammad Zahoor. 2022. "Phytochemical, Antimicrobial and Cytotoxic Activities of Gaultheria Trichophylla Royle" Applied Sciences 12, no. 14: 6921. https://doi.org/10.3390/app12146921
APA StyleZaman, S., Al-Joufi, F. A., Zafar, M., & Zahoor, M. (2022). Phytochemical, Antimicrobial and Cytotoxic Activities of Gaultheria Trichophylla Royle. Applied Sciences, 12(14), 6921. https://doi.org/10.3390/app12146921








